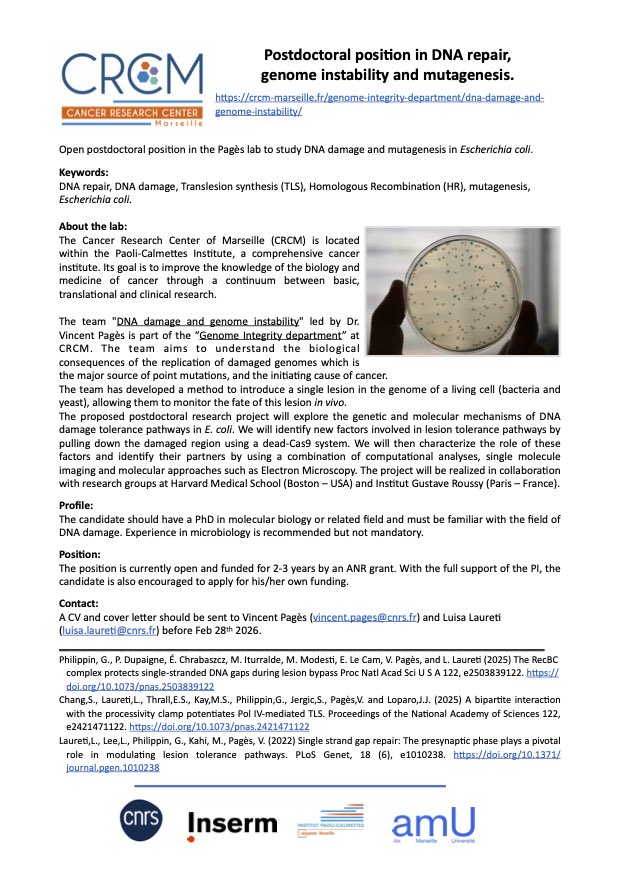
PagèsLab tweet media

PagèsLab
189 posts

PagèsLab
@Pages_Lab
DNA damage and genome instability group at @crcm_marseille. #DNAdamage, #TranslesionSynthesis, #HomologousRecombination, in bacteria & yeast
Marseille - France Katılım Eylül 2019
326 Takip Edilen723 Takipçiler

New paper out! We show that RecBC remodels single-stranded DNA gaps to protect them from ExoI (sbcB) 3′-5′ exonuclease degradation during replication of damaged DNA.
doi.org/10.1073/pnas.2…
English
PagèsLab retweetledi

#ResultatScientifique 🔎| Découvrez la dernière publication de Vincent Pagès et ses collaborateurs ⤵️
🤝 @CNRS @CNRS_dr12 @crcm_marseille @Pages_lab
📕 @NAR_Open | buff.ly/dmZPFD3

Français

Our latest article, in collaboration with Helle Ulrich, explores how the timing of lesion bypass and gap processing impacts genome stability.
doi.org/10.1093/nar/gk…

English

How does Pol IV overcome strong replication blocks in E. coli? Our latest study with @JoeLoparo uncovers a bipartite clamp interaction that helps Pol IV compete with Pol III, enabling efficient TLS at stalled forks and reducing mutagenesis.
buff.ly/3Xbgjxd

English
PagèsLab retweetledi
PagèsLab retweetledi

Join the conversation and get your abstract in soon!
Keystone Symposia@KeystoneSymp
Join Dr. Helle D. Ulrich & experts this April to explore DNA replication errors, breaks, repair, and cancer! Submit abstracts and scholarships by Jan. 28 (11:59pm MST)! hubs.la/Q032vtpl0 #KSDNARep25 #DNA #DNAreplication #DNAreplicationgaps #cancer @CantorLab @CicciaAlberto
English
PagèsLab retweetledi

📣 Register now until March 2nd, 2025, for the next Genome Instability and Human Disease international course at @institut_curie! Gain knowledge of mechanisms ensuring genome stability, from fundamental molecular pathways up to large scale approaches.
▶️training.institut-curie.org/courses/genome…

English
PagèsLab retweetledi

The versatile REV7 protein plays important roles in cancer development and chemotherapy resistance. Our lab's own Lara Maggs just published a comprehensive review of REV7 biology in a Frontiers issue collated by @lab_chatterjee. Check it out here: frontiersin.org/articles/10.33….
English
PagèsLab retweetledi

We are organizing a FREE small symposium on DNA replication and replication stress on December 2nd and 3rd in Montpellier, France. Slots are still available for posters and talks. More info here: replication.sciencesconf.org
English
PagèsLab retweetledi

We are pleased to inform you that the meeting “From Genome Instability to Cancer: A tribute to Angelos Constantinou” that will take place in Carry-Le-Rouet from March 10th to March 13th 2025 is now open for registration on the link: tribute2angelos.fr/page/home/

English
PagèsLab retweetledi

🧬#DNAreplication: the mystery unravels🧬
Looking forward to the EMBO/EMBL Symposium #EESreplication, which starts today!
@EMBLEvents

English
PagèsLab retweetledi

🧬 Join us tomorrow for an exciting seminar by @Terence_Strick, Full Professor at @ENS_ULM! He will present on “A DNA scaffold to study the repair of double-strand breaks.”
🗓️ Tuesday, Sept 24th, 2024
🕚 11:00 AM
📍 IPC2 Amphitheater
💻 Zoom: univ-amu-fr.zoom.us/j/87002272745?…
#DNArepair

English
PagèsLab retweetledi

New review article, written by Lewis Bainbridge @LewisBainb53268 and me. This article
focuses on the diverse roles of replicative DNA polymerases during genome replication and their molecular basis.
sciencedirect.com/science/articl…

English
PagèsLab retweetledi

I am glad to share our last work uncovering MCM/RNR interactions and their role in genome integrity
journals.plos.org/plosgenetics/a…
English